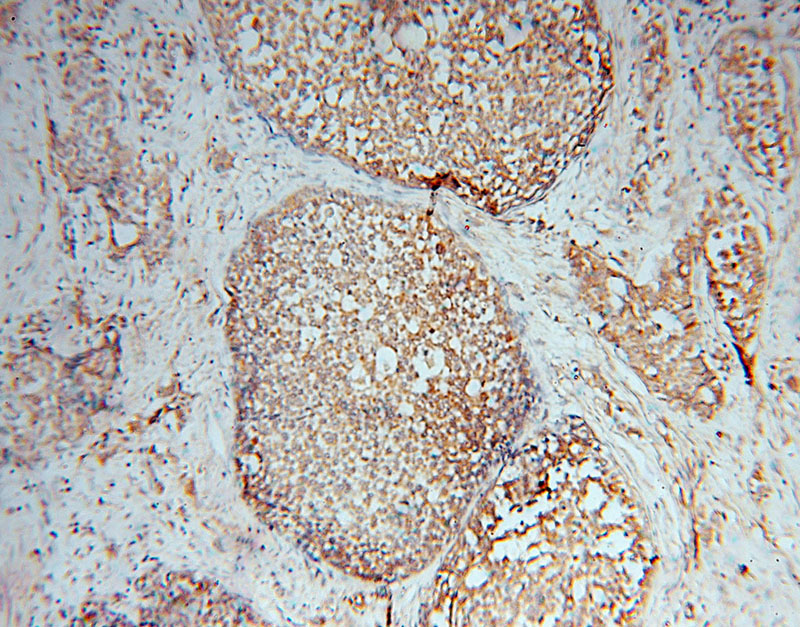
Immunohistochemical of paraffin-embedded human breast cancer using Catalog No:112833(MRPL49 antibody) at dilution of 1:50 (under 10x lens)

-
Product Name
MRPL49 antibody
- Documents
-
Description
MRPL49 Rabbit Polyclonal antibody. Positive IHC detected in human breast cancer tissue. Positive WB detected in BxPC-3 cells, A549 cells, HeLa cells. Positive IP detected in HeLa cells. Observed molecular weight by Western-blot: 19 kDa
-
Tested applications
ELISA, WB, IHC, IP
-
Species reactivity
Human; other species not tested.
-
Alternative names
C11orf4 antibody; L49mt antibody; MRP L49 antibody; MRPL49 antibody; Neighbor of FAU antibody; NOF antibody; NOF1 antibody; Protein NOF1 antibody
-
Isotype
Rabbit IgG
-
Preparation
This antibody was obtained by immunization of MRPL49 recombinant protein (Accession Number: NM_004927). Purification method: Antigen affinity purified.
-
Clonality
Polyclonal
-
Formulation
PBS with 0.02% sodium azide and 50% glycerol pH 7.3.
-
Storage instructions
Store at -20℃. DO NOT ALIQUOT
-
Applications
Recommended Dilution:
WB: 1:200-1:2000
IP: 1:200-1:2000
IHC: 1:20-1:200
-
Validations

BxPC-3 cells were subjected to SDS PAGE followed by western blot with Catalog No:112833(MRPL49 antibody) at dilution of 1:800
Immunohistochemical of paraffin-embedded human breast cancer using Catalog No:112833(MRPL49 antibody) at dilution of 1:50 (under 10x lens)

Immunohistochemical of paraffin-embedded human breast cancer using Catalog No:112833(MRPL49 antibody) at dilution of 1:50 (under 40x lens)

IP Result of anti-MRPL49 (IP:Catalog No:112833, 4ug; Detection:Catalog No:112833 1:500) with HeLa cells lysate 3360ug.
-
Background
MRPL49, also named as C11orf4, NOF1, or SW-cl.67, is a 166 amino acid protein, which belongs to the ribosomal protein L49em family. MRPL49 localizes in the Mitochondrion and is widely expressed in various tissues. MRPL49 is a regulator of C3 convertase of classical pathway.
-
References
- Wanschers BF, Szklarczyk R, Pajak A. C7orf30 specifically associates with the large subunit of the mitochondrial ribosome and is involved in translation. Nucleic acids research. 40(9):4040-51. 2012.
- Rajala N, Gerhold JM, Martinsson P, Klymov A, Spelbrink JN. Replication factors transiently associate with mtDNA at the mitochondrial inner membrane to facilitate replication. Nucleic acids research. 42(2):952-67. 2014.
- Yamamoto K, Gandin V, Sasaki M. Largen: a molecular regulator of mammalian cell size control. Molecular cell. 53(6):904-15. 2014.
- Gerhold JM, Cansiz-Arda Ş, Lõhmus M. Human Mitochondrial DNA-Protein Complexes Attach to a Cholesterol-Rich Membrane Structure. Scientific reports. 5:15292. 2015.
Related Products / Services
Please note: All products are "FOR RESEARCH USE ONLY AND ARE NOT INTENDED FOR DIAGNOSTIC OR THERAPEUTIC USE"
